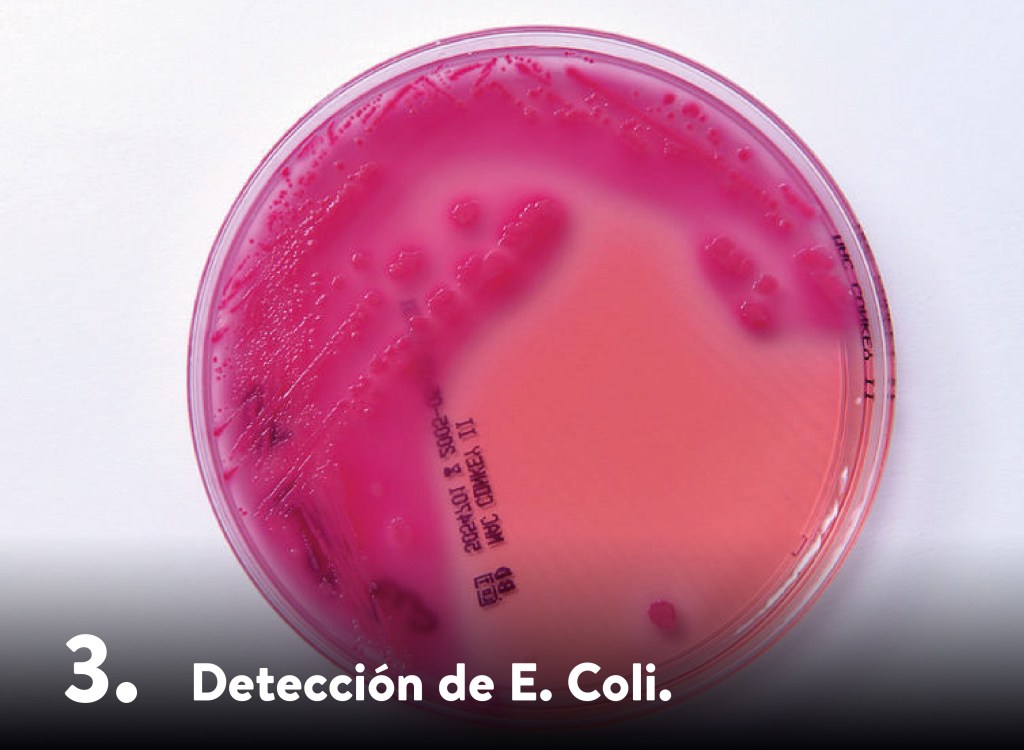
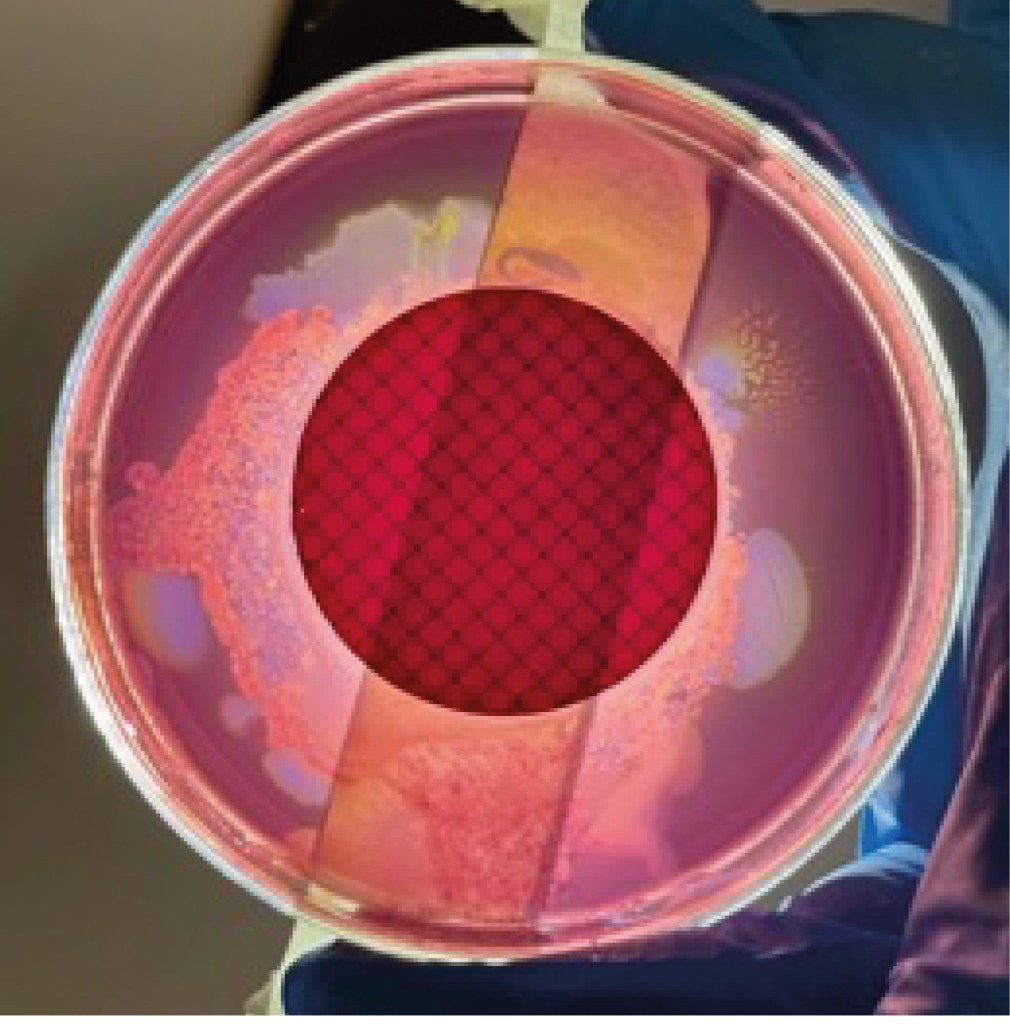

Caracterización fisicoquímica y microbiológica de la quebrada, aula ambiental del Colegio Colombo Sueco, Usaquén, Bogotá, Colombia- Área circundante al Gimnasio Campestre
- Docente de ña Red de Diseño y Desarrollo, Gimnasio Campestre
Correspondencia para los autores: pwroblewska@campestre.edu.co, camaya@campestre.edu.co, ncarretero@campestre.edu.co
Recibido: 21 de marzo de 2023
Aceptado: 5 de mayo de 2023

Table of Contents
RESUMEN
La calidad del agua se puede caracterizar mediante factores que abarcan sus propiedades químicas, físicas y biológicas, definiendo así su idoneidad para diversos fines. La calidad de las fuentes de agua se presenta como un indicador destacado de la salud de un ecosistema, influyendo en el entorno que se configura a partir de ella. Con el objetivo de analizar la calidad del agua, se realizó la caracterización fisicoquímica y microbiológica del afluente de origen natural, en la localidad de Usaquén, Bogotá, Colombia. En este trabajo se realizaron 4 muestreos del afluente, durante un período de 4 semanas entre noviembre y diciembre del 2022. Se analizaron las características fisicoquímicas evaluando los niveles de O2 disuelto, fósforo reactivo (ortofosfato), nitrito, nitrato y nitrógeno amoniacal (usando kits específicos y leyendo las muestras en un espectrofotómetro portátil Hach DR-1900); y microbiológicas, específicamente la presencia de bacterias coliformes, como E. coli, a través del método de filtración por membrana de nitrato de celulosa, tamaño de poro de 0,45 µm e incubadas sobre medio agar Condalab MacConkey Agar N°2, a 35 ± 1°C por un período de 24h. Adicional a esto se realizó tinción de Gram para confirmar el hallazgo. Se encontraron altos niveles de nitrato, nitrito, fosfato, amoníaco, valores por encima de los límites permitidos por la ley colombiana para cuerpos de agua de este tipo. Se confirmó la presencia de bacterias E. coli. Estos hallazgos sugieren posible contaminación por fertilizantes, descargas de aguas residuales, materia orgánica y/o contaminación fecal de origen humano y animal presentando un riesgo para el ecosistema acuático y la salud pública. Se propone realizar un análisis exhaustivo del vallado, identificar las fuentes de contaminación y abordar los impactos ambientales.
Palabras clave: calidad del agua, nitrógeno total, fosfato, bacterias.
ABSTRACT
The quality of water can be characterized by factors that encompass its chemical, physical, and biological properties, thus defining its suitability for various purposes. The quality of water sources stands out as a prominent indicator of the health of an ecosystem, influencing the environment that develops from it. With the objetive of analize the quality of the water, physicochemical and microbiological characterization of the natural-origin tributary was carried out in the Usaquén locality, Bogotá, Colombia. In this study, four samplings of the tributary were conducted over a period of four weeks between November and December 2022. The physicochemical characteristics were analyzed, evaluating levels of dissolved oxygen, reactive phosphorus (orthophosphate), nitrite, nitrate, and ammonia nitrogen (using specific kits and reading samples on a portable Hach DR-1900 spectrophotometer). Microbiological assessments were also performed, specifically examining the presence of coliform bacteria such as E. coli through the cellulose nitrate membrane filtration method with a pore size of 0.45 µm, incubated on Condalab MacConkey Agar No. 2 medium at 35 ± 1°C for a period of 24 hours. Gram staining was additionally conducted to confirm the findings. Elevated levels of nitrate, nitrite, phosphate, and ammonia were found, exceeding the limits allowed by Colombian law for bodies of water of this type. The presence of E. coli bacteria was confirmed. These findings suggest possible contamination from fertilizers, wastewater discharges, organic matter, and/or fecal contamination of human and animal origin, posing a risk to the aquatic ecosystem and public health. It is proposed to conduct a comprehensive fencing analysis, identify sources of contamination, and address environmental impacts.
Key Words: water quality, total nitrogen, phosphate, bacteria.
«La calidad del agua puede definirse como aquellos factores que describe las características químicas, físicas y biológicas del agua y determinan el posible uso que se le puede dar»

INTRODUCCIÓN
El agua es denominada el recurso más invaluable de nuestro planeta, gracias a él, la vida se desarrolla tal cual la conocemos. Aunque nuestro planeta está conformado por tres cuartas partes de agua, alrededor de unos 1386 millones de km2. De esta cantidad se estima que el 97% es agua salada y solo el 2,5% se considera dulce. De este último porcentaje, el agua disponible se reduce alrededor de solo el 0,5%, distribuida entre depósitos subterráneos, agua congelada y cuencas hidrográficas y solo el 0,025% de esta es potable. Por lo tanto, solo el 0,007% del agua existente en la tierra es potable (Fundación Aquae, 2021). El desarrollo de la humanidad ha hecho que este recurso, que antes se pensaba como renovable, haya entrado en crisis. Las fuentes de agua disponibles se están agotando y las pocas que quedan están siendo afectadas por la creciente contaminación, reduciendo dramáticamente su ya escasa disponibilidad.
El agua desempeña un papel crucial en nuestra vida, siendo esencial tanto para nuestros procesos metabólicos básicos (Vaquero, et al., 2012) como para mantener los ecosistemas, participando en procesos fotosintéticos y asegurando la vitalidad de diversos organismos y sus hábitats. Además, influye en la regulación de la temperatura terrestre, la estabilidad climática, la producción de oxígeno y el transporte de nutrientes a través de los ecosistemas, afectando el crecimiento de los organismos y el flujo de energía (Moss, 2013). Dada su importancia y la actual escasez, el monitoreo de los afluentes remanentes se vuelve crucial para desarrollar programas de manejo y conservación del agua (Sustentabilidad, 2021).
La calidad del agua puede definirse como aquellos factores que describe las características químicas, físicas y biológicas del agua y determinan el posible uso que se le puede dar (Torres, et al., 2009). La calidad de dichas fuentes es un excelente indicador de la salud de un ecosistema y determina el entorno que se desarrolla a partir de esta. A medida que los ecosistemas han sido intervenidos por la expansión humana, dichos afluentes se han visto afectados en cantidad y calidad, lo que ha cambiado el componente biológico en su interior, así como a su alrededor (Fernández, 2012). Hacer la caracterización, análisis y monitoreo, de estos sistemas, nos permite determinar su funcionalidad y afectación para determinar su utilidad e impacto. La caracterización de estos cuerpos de agua y el análisis de su estado acuático son cruciales para determinar su funcionalidad y afectación, especialmente en áreas urbanas como la zona del colegio Colombo Sueco en Usaquén, Bogotá. La alta ocupación urbana ha generado una marcada afectación ambiental, fragmentando significativamente el ecosistema y provocando la pérdida de componentes biológicos importantes. La caracterización de este único espacio remanente permitirá identificar posibles planes de integración y conservación. Las preguntas fundamentales abordan el estado actual fisicoquímico, microbiológico y trófico de la quebrada dentro del aula ambiental del colegio, circundante al Gimnasio Campestre.
Se destaca la importancia del agua como recurso invaluable y su actual crisis debido a la escasez y contaminación. Además de ser vital para procesos metabólicos y reacciones químicas corporales, el agua desempeña un papel crucial en el mantenimiento de ecosistemas, la regulación de la temperatura terrestre, la estabilidad climática, la producción de oxígeno y el transporte de nutrientes a través de los ecosistemas. Frente a la escasez y afectación del recurso, el monitoreo de afluentes remanentes es esencial para garantizar su calidad. En el caso de los afluentes cerca del Gimnasio Campestre, el análisis busca determinar la interacción de la comunidad con estos cuerpos de agua, evaluando el impacto diario y orientando programas para el manejo y conservación de estos espacios. Los objetivos generales y específicos se centran en la caracterización preliminar fisicoquímica y microbiológica, de las aguas de la quebrada, con el análisis de la presencia de microorganismos, elementos y nutrientes, así como elementos contaminantes.
Para el caso de los afluentes que rodean el Gimnasio Campestre, es importante dicho análisis pues podremos determinar cómo interactúa nuestra comunidad con el mismo, es decir, si nuestro día a día está generando impactos positivos o negativos que determinan la transformación de nuestro ecosistema circundante, esto encaminado a generar programas que permitan el manejo y conservación de dichos espacios.
El agua, como componente vital para la vida en la Tierra y la conservación de especies, posee propiedades únicas que la destacan, como su alta capacidad calorífica, tensión superficial elevada y capacidad de disolver diversas sustancias. Su importancia se extiende a la regulación climática y la preservación de ecosistemas acuáticos (Campbell, et al. 2005). Las propiedades fisicoquímicas del agua, como la temperatura, conductividad, pH, materia orgánica, iones y oxígeno disuelto, son fundamentales para influir en su calidad y la salud de los ecosistemas acuáticos (Fernández, 2012; Chang, 2010).
La alteración de estas propiedades puede tener efectos negativos en la biodiversidad y en la capacidad de los ecosistemas acuáticos para proporcionar servicios ecosistémicos esenciales, como la purificación del agua y la regulación del clima. El decreto 190 de 2004 subraya la importancia de los sistemas hídricos en el Plan de Ordenamiento Territorial (POT) de Bogotá, destacando su función vital y su contribución a la conservación de la biodiversidad. Se resalta la responsabilidad de la Secretaría Ambiental de Bogotá y los alcaldes locales para tomar medidas necesarias para la conservación y recuperación de estas zonas acuáticas (APHA – AWWA, 2017).
Los métodos analíticos de monitoreo de calidad del agua son esenciales para evaluarla y detectar posibles fuentes de contaminación, siendo útiles para establecer límites y evaluar la efectividad de las medidas de gestión. No obstante, la evaluación a largo plazo requiere considerar las comunidades acuáticas, ya que proporcionan información más completa sobre la calidad del agua en el tiempo. Factores como aguas negras domésticas, procesos agropecuarios e industriales, y mal manejo de residuos pueden causar variaciones en las características fisicoquímicas y biológicas de los sistemas hídricos (APHA – AWWA, 2017).
La determinación de estos parámetros permite hacer un diagnóstico preliminar de las fuentes de agua y posterior monitoreo o proposición de planes de tratamiento de las mismas. Adicionalmente, seguimientos de este tipo a nivel ecológico, tienen un impacto significativo pues pueden guiar en la determinación de las relaciones entre los ecosistemas acuáticos y su entorno, así como el impacto de su estado frente al ecosistema en general. Por último, la implementación de este tipo de estudios en busca del manejo y conservación de fuentes de agua, siempre tendrán un impacto positivo a nivel ecológico in situ y en este caso en el área circundante, que corresponde al área ocupada por el Gimnasio Campestre.

MARCO METODOLÓGICO
Zona de análisis:
El área de estudio corresponde al vallado ubicado en el borde norte del predio del colegio (Coordenadas de posicionamiento geográfico: 4,7434727, -74,0271657), zona la cual presenta una amplia extensión (alrededor de 300 metros de longitud) y que aun presenta características no alteradas. La caracterización de este único espacio remanente proveerá de un diagnóstico preliminar del área y con este, se podrán determinar a futuro, posibles planes de integración del área al espacio escolar, manejo y conservación del mismo.

Toma de muestras: Se realizaron 4 muestreos durante un período de 4 semanas entre 10 de noviembre 2022 a 1 de diciembre 2022.
Mediciones de campo y muestreos
Se realizaron 4 muestreos de agua durante un período de 4 semanas entre 10 de noviembre 2022 a 1 de diciembre 2022.
Los parámetros de campo como la temperatura del agua, la velocidad de la corriente y la profundidad del arroyo se midieron en los 3 puntos de muestreo.
Cada muestra se recolectó en un recipiente de agua de plástico opaco limpio con una fecha y ubicación claramente especificadas. Las muestras fueron almacenadas a temperatura ambiente hasta su análisis el mismo día en un período menor a 3 horas desde el momento de la recolección.

Las muestras de agua se analizaron con un espectrofotómetro portátil Hach DR 1900 para O2 disuelto, fósforo reactivo (ortofosfato), nitrito, nitrato y nitrógeno amoniacal. Se utilizó agua desionizada como estándar para la calibración del espectrofotómetro. Los límites de detección para cada elemento fueron 15,0 mg/L para oxígeno disuelto, 2,50 mg/L para fósforo reactivo (ortofosfato), 0,300 mg/L para nitrito, 30,0 mg/L para nitrato, 0,50 mg/L para nitrógeno amoniacal. Los resultados se registraron y se utilizaron para calcular la media y la desviación estándar.
Las muestras se recolectaron el mismo día en 2 lugares diferentes a lo largo del arroyo. Para cada punto de muestreo se recogieron 5 muestras de 200 ml de agua. El agua se recolectó en recipientes opacos y se almacenó en refrigeración hasta el momento del análisis.
La presencia de E. Coli se analizó mediante el método de filtración por membrana. Las muestras de agua se pasaron a través de un filtro de membrana de nitrato de celulosa estéril con un tamaño de poro de 0,45 µm. El filtro de membrana se incubó sobre medio agar Condalab MacConkey Agar N°2, a 35 ± 1°C por un período de 24h. Se contaron las colonias incubadas de bacterias coliformes fecales. De cada placa de agar incubada se aislaron 2 colonias de coliformes fecales para un análisis cuantitativo y cualitativo adicional.
Se usó el método de Gram básico para teñir colonias aisladas y visualizar las células bacterianas. Las muestras montadas se secaron y luego se observaron bajo un microscopio (aumento x40).

ANÁLISIS Y RESULTADOS
En las siguientes gráficas (1-8) se encuentran los datos para cada uno de los análisis realizados en las cuatro diferentes fechas y en cada uno de los puntos de análisis.
El análisis de las condiciones físicas de un cuerpo de agua es esencial para comprender su funcionamiento y su capacidad de sustentar la vida acuática. En este estudio, se evaluaron tres parámetros clave: profundidad (gráfico 1), temperatura (gráfico 2) y velocidad (gráfico 3). Los resultados revelaron que estos factores se mantienen consistentemente por debajo de ciertos valores. Los resultados de las mediciones indicaron que la profundidad del cuerpo de agua nunca supera los 15 cm. Además, se observó que la temperatura se mantiene constantemente por debajo de los 16 grados centígrados, y la velocidad del agua nunca supera los 0,4 m/s.

Gráfico 1: Profundidad del agua (cm) en distintos puntos y fechas de análisis

Gráfico 2: Temperatura del agua en distintos puntos y fechas de análisis

Gráfico 3: Velocidad del agua (m/s) en distintos puntos y fechas de análisis
Las condiciones encontradas en este cuerpo de agua plantean importantes consideraciones para el ecosistema acuático. La profundidad limitada puede tener implicaciones significativas para la disponibilidad de hábitats adecuados y refugios para la vida acuática. (Vaquero, et al., 2012; Moss, 2013) Los organismos que requieren áreas más profundas para reproducirse, alimentarse o evitar depredadores podrían verse afectados negativamente por la falta de hábitats adecuados. La temperatura constante por debajo de los 16 grados centígrados puede influir en la actividad biológica y la tasa de metabolismo de los organismos acuáticos. Las temperaturas más bajas pueden ralentizar los procesos biológicos y limitar la diversidad y la abundancia de especies adaptadas a temperaturas más cálidas. Además, ciertos organismos pueden tener dificultades para reproducirse o desarrollarse adecuadamente en condiciones de temperatura más fría. La baja velocidad del agua también puede afectar el transporte de nutrientes, sedimentos y organismos en el cuerpo de agua. Una velocidad de flujo reducida puede limitar la circulación de agua y la mezcla de oxígeno, lo que a su vez puede afectar la disponibilidad de nutrientes y el equilibrio ecológico en el ecosistema acuático (Moss, 2013). Es importante considerar que estas condiciones pueden ser el resultado de factores naturales, como la topografía del terreno, la presencia de obstáculos físicos apreciables a simple vista o la temporada del año. Sin embargo, también es esencial evaluar si hay influencias humanas que están contribuyendo a estas condiciones anómalas y potencialmente perjudiciales.
El fósforo es un nutriente esencial para el crecimiento de los organismos acuáticos, pero su exceso puede provocar problemas de calidad del agua, como la eutrofización. En este estudio, se analizó un cuerpo de agua para determinar los niveles de iones fosfato (gráfico 4) y se compararon con los estándares establecidos (Bolaños, et al., 2017). Los resultados revelaron concentraciones superiores al límite máximo admisible (gráfico 4), lo que indica una posible contaminación y la necesidad de investigar sus causas. Los análisis realizados en tres ubicaciones del cuerpo de agua y en cuatro fechas diferentes mostraron consistentemente concentraciones de iones fosfato por encima del límite máximo admisible establecido por las regulaciones ambientales. (IDEAM –2, 2023) Estos valores elevados indican un desequilibrio en el ciclo del fósforo y sugieren una entrada excesiva de fuentes externas al cuerpo de agua. Existen varias posibles fuentes de contaminación con iones fosfato en el cuerpo de agua estudiado. Una de ellas podría ser la descarga de aguas residuales domésticas y agrícolas sin tratamiento adecuado. Estas aguas pueden contener fertilizantes y detergentes que contienen fósforo, los cuales pueden filtrarse en el cuerpo de agua y elevar sus concentraciones de iones fosfato.

Gráfico 4: Concentración de fosfato (mg/L) en el agua en distintos puntos y fechas de análisis
Otra fuente potencial podría ser la escorrentía de tierras agrícolas donde se han aplicado grandes cantidades de fertilizantes fosfatados, como el fosfato diamónico que es un fertilizante sólido que se aplica directamente sobre el terreno generando una alta concentración de nitrógeno y fósforo. Y es muy apreciado por todo agricultor por la relación precio/beneficio. Durante las precipitaciones, los excesos de fertilizantes pueden ser arrastrados hacia el cuerpo de agua, aumentando así las concentraciones de iones fosfato. Además, la presencia de sistemas de drenaje inadecuados en las áreas circundantes, como por ejemplo el hospital Simón Bolívar puede facilitar el transporte de fósforo hacia el cuerpo de agua.
Es importante destacar que las altas concentraciones de iones fosfato pueden desencadenar el crecimiento excesivo de algas y plantas acuáticas, lo que puede agotar el oxígeno del agua y causar efectos negativos en la fauna acuática, incluida la disminución de especies sensibles y la alteración del equilibrio ecológico.
En resumen, aunque en Colombia no existen las normas claras sobre los limites de la concentración de los fosfatos en afluentes, sin embargo el IDEAM usa la norma Colombiana Resolución 2115 de 2007, en el artículo 7º (IDEAM –2, 2023) para determinar el valor de 0,5 mg/L de PO4-3 como el limite admisible para consumo humano. Debido a la importancia de los fosfatos en la eutrofización de los sistemas acuáticos, países como Costa Rica establecieron el valor de de 0,10 mg/L de PO4-3 como un indicador de altera en los ecosistemas (Bolaños, et al., 2017). Diez de las muestras analizadas presentaron niveles de concentración PO4-3 mayores al los limites de alerta establecidos.
Los nitratos y nitritos son compuestos nitrogenados que se encuentran naturalmente en el agua, pero altas concentraciones de estos iones pueden indicar contaminación y representar un riesgo para el ecosistema acuático y la salud humana. Este estudio, se analizaron los niveles de nitrato y nitrito (gráficos 5, 6) en tres ubicaciones diferentes y en cuatro fechas distintas, y se compararon con los límites máximos admisibles establecidos. (IDEAM –1, 2023) Los resultados revelaron concentraciones superiores, lo que indica una posible contaminación. Estos valores elevados sugieren la presencia de fuentes externas de contaminación que están introduciendo nitratos y nitritos en el cuerpo de agua en cantidades superiores a las toleradas. Existen varias posibles fuentes de contaminación con nitratos y nitritos en el cuerpo de agua estudiado. Una fuente común en especial en la sabana cundiboyacense es la actividad agrícola, donde se utilizan fertilizantes y se aplican productos químicos nitrogenados para aumentar la productividad de los cultivos. Durante las lluvias o el riego, estos compuestos pueden lixiviar hacia el cuerpo de agua, elevando así las concentraciones de nitrato y nitrito. Otra fuente potencial de contaminación y en este caso la más probable es la descarga de aguas residuales no tratadas o insuficientemente tratadas. Las aguas residuales domésticas y afluentes industriales pueden contener altas concentraciones de nitratos y nitritos, que pueden infiltrarse en el cuerpo de agua y contribuir a los valores por encima del límite máximo admisible.

Gráfico 5: Concentración de nitrato (mg/L) en el agua en distintos puntos y fechas de análisis

Gráfico 6: Concentración de nitrito (mg/L) en el agua en distintos puntos y fechas de análisis
Es importante destacar que las altas concentraciones de nitratos y nitritos pueden tener impactos significativos en el ecosistema acuático. Estos compuestos actúan como nutrientes y pueden promover el crecimiento excesivo de algas y plantas acuáticas, provocando la eutrofización y el agotamiento del oxígeno en el agua. Esto puede resultar en la muerte de organismos acuáticos y cambios en la composición de las comunidades biológicas. Estos posibles escenarios también son apoyados por la alta concentración de iones fosfato discutida anteriormente.
Además, la presencia de nitratos y nitritos en el agua potable puede representar un riesgo para la salud humana. Altas concentraciones de nitratos pueden dar lugar a la formación de nitritos en el cuerpo humano, lo que puede interferir con la capacidad de transportar oxígeno en la sangre y representar un riesgo especial para los bebés. (Ma, 2018)
Los resultados de estos análisis muestran la presencia de concentraciones de nitratos y nitritos por encima del límite máximo admisible en un cuerpo de agua, (IDEAM – 1, 2023; Bolaños, et al., 2017) lo que indica una contaminación significativa.
El análisis de los parámetros químicos de las aguas permite entender mejor el origen de las aguas y las posibles fuentes de contaminación. Es muy importante conocer los limites establecidos tanto por organizaciones internacionales como por el gobierno colombiano frente a la concentración de ciertos contaminantes para poder evaluar el estado del cuerpo acuático y poder identificar la necesidad de monitoreo.
Ahora resumiendo, en el caso de la cantidad de nitrógeno total, lo que incluye nitrito, nitrato y amoniaco la resolución 2115 de 2007, del Ministerio de Ambiente, Vivienda y Desarrollo Territorial y del Ministerio de la Protección Social, establece que la concentración de nitritos debe ser menor o igual a 0,1 mg/L de NO2– y la concentración de nitratos debe ser menor o igual a 10 mg/L de NO3– (IDEAM – 1, 2023). En caso de nitrato, dentro de las 12 muestras analizadas 11 estaban por encima del valor de concentración admisible. En caso de nitrito todas las 12 muestras evidenciaron la concentración mayor al nivel admisible.
El Decreto 1594 de 1984, de la Presidencia de la República de Colombia, establece que el valor máximo admisible para la presencia de amoniaco en aguas para consumo humano y domestico no debe ser mayor al 1 mg/L. Aunque existen diferencias en la concentración de amoniaco de los dos primeros muestreos y los dos siguientes, todos los valores demuestra estar por encima del valor máximo admisible para ese componente químico.
Este estudio reveló que el cuerpo de agua en cuestión presenta concentraciones de amoníaco que superan el límite admisible de 1,0 mg/L (gráfico 7). Encontramos niveles de amoníaco significativamente más altos, alcanzando hasta 4,5 mg/L. Esta concentración elevada puede resultar tóxica para los organismos acuáticos sensibles y tener un impacto negativo en su salud y supervivencia. Además, observamos que los niveles de oxígeno disuelto en el agua también excedían el límite admisible de 5,0 mg/L (gráfico 8).

Gráfico 7: Concentración de amoniaco (mg/L) en el agua en distintos puntos y fechas de análisis

Gráfico 8: Concentración de oxígeno (mg/L) en el agua en distintos puntos y fechas de análisis
Se analizaron las posibles fuentes de contaminación en el cuerpo de agua. Como se mencionó anteriormente actividades humanas, como la descarga de aguas residuales sin tratar y el uso de fertilizantes en las áreas cercanas, podrían estar contribuyendo a las altas concentraciones de amoníaco. Estas sustancias químicas ingresan al cuerpo de agua a través del escurrimiento superficial y los afluentes, agravando aún más el problema. Con base en nuestros hallazgos, es evidente que se requieren acciones urgentes para abordar esta situación. Es fundamental implementar medidas de gestión adecuadas, como la mejora de la infraestructura de tratamiento de aguas residuales, el monitoreo regular de la calidad del agua y la promoción de prácticas agrícolas sostenibles para minimizar la entrada de sustancias químicas al cuerpo de agua.
La norma Colombiana Decreto 1076 de 2015 establece los valores de oxígeno disuelto para preservación de flora y fauna: 5,0 mg/L en aguas dulces frías y 4,0 mg/L en aguas dulces cálidas (IDEAM – 3, 2023). En todas las muestras analizadas se observo valores superiores al valor mínimo admisible para destinación de recurso para la preservación de fauna y flora.
En el estudio, también se llevó a cabo un análisis de la presencia de microorganismos patógenos. La detección de E. coli y otras bacterias coliformes, puede utilizarse como un indicador de la calidad de los cuerpos de agua y la posible contaminación por aguas residuales. Estos microorganismos son señales claras de la presencia de fuentes de contaminación potencialmente peligrosas.
Escherichia coli (E. coli) es una bacteria gram negativa que se encuentra comúnmente en el tracto digestivo y las heces de muchos animales, incluyendo los seres humanos. En este estudio, se observó una alta presencia y concentración de E. coli en las tres muestras analizadas, lo cual indica la presencia de materia fecal de origen humano o animal en el agua. Aunque no se pudo determinar la cantidad exacta de colonias presentes debido a la concentración en el medio de crecimiento (Imagen 1), se puede confirmar la presencia de este tipo de bacterias, el medio selectivo utilizado para su cultivo las muestra de color rojo, como corresponde a lo descrito en la literatura y se puede concluir entonces, que el alto nivel de crecimiento y concentración de E. coli se debe a la contaminación de las aguas.
Por otro lado, al utilizar el método de tinción Gram, se pudo identificar y confirmar la presencia de E. coli y otros coliformes en las muestras de agua analizadas, como se muestra en la Imagen 2. Además, en el análisis microscópico también se observó la posible presencia de bacterias fecales gram positivas, tal como se evidencia en la Imagen 3. Estos hallazgos refuerzan la evidencia de contaminación fecal en las muestras de agua evaluadas. La detección de estas bacterias indica la necesidad de implementar medidas adecuadas de tratamiento y control para prevenir riesgos para la salud pública y garantizar la calidad del agua en los sistemas estudiados. Es esencial realizar un seguimiento continuo y riguroso de la presencia de estas bacterias para tomar decisiones informadas y aplicar estrategias de gestión apropiadas.

Imagen 1: Colonias incubadas sobre medio agar Condalab MacConkey Agar N°2

Imagen 2: Imagen microscópica en magnificación x40 donde se evidencia la presencia de E. coli. Barra de medición correspondiente a 5

Imagen 3: Imagen microscópica en magnificación x40 se bacterias Gram positivas de posible origen fecal. Barra de medición correspondiente a 5 mm.
CONCLUSIONES
- En conclusión, la detección de altas concentraciones de nitritos, nitratos, fosfatos y amoniaco indica la presencia de contaminación por aguas residuales y fuentes de materia fecal y fertilizantes. Estos compuestos son claros indicadores de la contaminación del agua, amenazando la calidad y salud del ecosistema acuático.
- La presencia de coli y otras bacterias coliformes es un claro indicador de la contaminación por aguas residuales, materia fecal y materia orgánica en descomposición. Estos microorganismos son característicos de fuentes de contaminación de origen humano y animal, representando un riesgo para la salud pública y el medio ambiente.
- A pesar de las condiciones adversas, se observa que el oxígeno disuelto se mantiene por encima del nivel mínimo requerido. Esto indica que el cuerpo de agua todavía cuenta con un suministro adecuado de oxígeno, aunque se debe monitorear de cerca debido a posibles cambios en la turbidez y velocidad del agua.
- Se reconoce la importancia de mantener niveles adecuados de los elementos estudiados para preservar la salud del cuerpo de agua. La superación de los niveles de fosfato puede desencadenar la eutrofización del sistema, afectando negativamente a la fauna y desequilibrando el ecosistema acuático.
En resumen, se propone realizar un análisis de la fauna y flora presente en el arroyo y sus alrededores, junto con un monitoreo estacional de la calidad del agua. Además, es crucial identificar las fuentes de contaminación y evaluar sus conexiones con nuestro arroyo. Estas acciones son fundamentales para comprender y abordar los impactos ambientales en el ecosistema acuático, promoviendo la protección de la biodiversidad, la salud del agua y la sostenibilidad a largo plazo del arroyo y sus ecosistemas circundantes.
REFERENCIAS
APHA, AWWA, & WEF. (2017). Standard methods for the examination of water and wastewater. American Public Health Association.
Bolaños, J. D., Cordero, G., Segura, G. (n.d.). Determinación de nitritos, nitratos, sulfatos y fosfatos en agua potable como indicadores de contaminación ocasionada por el hombre, en dos cantones de Alajuela (Costa Rica). Tecnología en Marcha, 30(4).
Campbell, N. A., & Reece, J. B. (2005). Biología. Pearson Educación.
Chang, R. (2010). Química. McGraw-Hill.
Cuánta agua potable hay en la Tierra? (2016, febrero 2). Fundación Aquae. https://www.fundacionaquae.org/wiki/cantidad-de-agua-potable-fuente-de-vida/
Fernández Cirelli, A. (2012). El agua: un recurso esencial. Química Viva, 11(3), 147-170. Retrieved May 31, 2023, from https://www.redalyc.org/articulo.oa?id=86325090002
Instituto de Hidrología, Meteorología y Estudios Ambientales IDEAM -1. Formato Común de Hoja Metodológica de Indicadores Ambientales Promedio de Nitrógenos totales.
Instituto de Hidrología, Meteorología y Estudios Ambientales IDEAM -3. Formato Común de Hoja Metodológica de Indicadores Ambientales Promedio de oxígeno disuelto.
Instituto de Hidrología, Meteorología y Estudios Ambientales IDEAM -2. Promedio de fósforo total (PFT).
Ma, L., Hu, L., Feng, X., & Wang, S. (2018). Nitrate and Nitrite in Health and Disease. Aging and disease, 9(5), 938–945. https://doi.org/10.14336/AD.2017.1207
Moss, B. R. (2013). Chapter 2: Water, a remarkable unremarkable substance. In Ecology of fresh waters: A view for the twenty-first century (pp. 10–24). Wiley-Blackwell.
Sustentabilidad. (2021). Agua.org.mx. Retrieved May 31, 2023, from https://agua.org.mx/sustentabilidad/
Torres, P., Cruz, C. H., & Patiño, P. J. (2009). Índices de calidad de agua en fuentes superficiales utilizadas en la producción de agua para consumo humano. Una revisión crítica. Revista Ingenierías Universidad de Medellín, 8(15).
Vaquero, M. P., & Toxqui, L. (2012). CAPÍTULO 3 Propiedades y funciones biológicas del agua. In Agua para la salud: Pasado, presente y futuro (pp. 33–45). Consejo Superior de Investigaciones Científicas.
